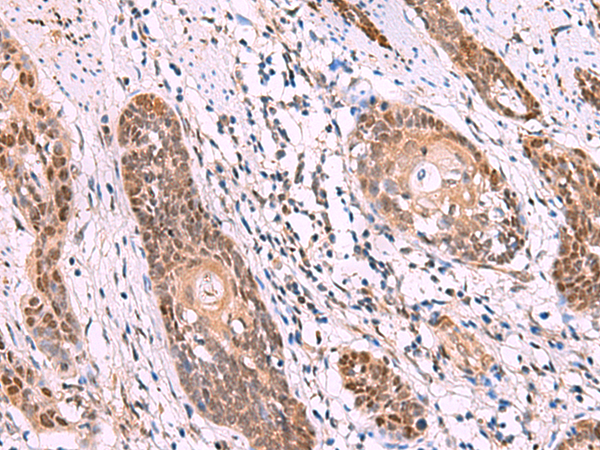

-
分类: 科研抗体货号: P07192别名: CRP1; C/EBP-epsilon应用: WB反应种属: Human, Mouse, Rat
-
分类: 科研抗体货号: P07169别名:应用: WB反应种属: Human
-
分类: 科研抗体货号: P07183别名: MCPH12; PLSTIRE应用: WB,IHC反应种属: Human, Mouse
-
分类: 科研抗体货号: P07191别名: GPE1BP; IG/EBP-1应用: WB,IHC反应种属: Human, Mouse, Rat
-
分类: 科研抗体货号: P07204别名: CLAX; LLT1; OCIL应用: IHC反应种属: Human
-
分类: 科研抗体货号: P07182别名: LIS7; PSSALRE应用: WB,IHC反应种属: Human, Mouse, Rat
-
分类: 科研抗体货号: P07190别名: CEACAM3, R29124_1应用: IHC反应种属: Human
-
分类: 科研抗体货号: P07203别名: MCL; MPCL; CD368; CLEC6; CLEC-6; CLECSF8; Dectin-3应用: WB,IHC反应种属: Human
-
分类: 科研抗体货号: P07181别名: CMM3; PSK-J3应用: WB,IHC反应种属: Human, Mouse, Rat
-
分类: 科研抗体货号: P07187别名: KIP1; MEN4; CDKN4; MEN1B; P27KIP1应用: WB,IHC反应种属: Human, Mouse

鄂公网安备42018502007531号
鄂公网安备42018502007531号

